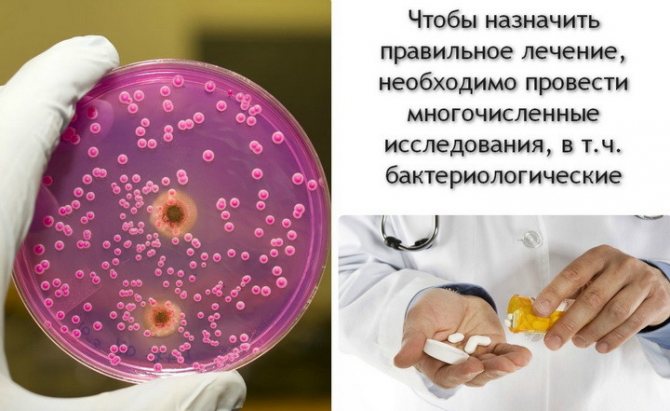
назначение лечения при кандидозе

Нерегулярная гигиена
Почему появляется неприятный запах из пупочной ямки? Очень часто причина кроется в элементарном несоблюдении личной гигиены, особенно если у человека глубокий пупок.
В нем скапливается грязь, пыль, частицы кожи и волос, ворс с одежды — все это приводит к появлению «пупочных катышков» — маленьких комочков шерсти, которые, если не мыться и не убирать их из пупка, могут преобразовываться в дурно пахнущую «грязевую пробку».
Варианты лечения
Остановимся и на том, как избавиться от запаха из пупка. Любое из диагностированных заболеваний и патологических состояний требует соответствующего лечения. Например:
- Пупочный свищ или киста – прямое показание к хирургическому вмешательству. В противном случае возможны серьезные осложнения.
- При омфалите и других воспалениях инфекционной природы врачи прибегают к консервативным терапевтическим методам. Основные принципы лечения при этом заболевании заключаются в регулярной обработке пупочного рубца антисептическими и антибактериальными препаратами, поддерживании сухости и чистоты тела.
- Если выделения из пупка – это следствие патологических процессов, вызванных сахарным диабетом, женщине необходимо пройти лечебный курс по снижению процентного содержания сахара в крови.


Заболевания, сопровождающиеся запахом из пупка
Вы следите за собой, но избавиться неприятного запаха не получается? Пупок не просто плохо пахнет, но из него выделяется жидкость? В этом случае необходимо обратиться к врачу. Есть целый ряд заболеваний, из-за которых в пупочной ямке может появиться неприятный запах.
Киста урахуса (киста мочевого пузыря)
Это заболевание представляет собой неправильное развитие мочевого протока, урахуса. Оно может появиться еще в период эмбрионального развития и долгое время никак не давать о себе знать.
Медицинские нормы гласят, что мочевой проток у ребенка должен зарастать на 5-6 месяце после его рождения, но иногда возникает патология, и в этом протоке появляется полое образование. Оно заполняется отходами жизнедеятельности, которые выводятся через пупочное отверстие.
Человек может долгое время жить с этой кистой и не подозревать о ней, но в какой-то момент (нередко это происходит и во взрослом возрасте) она все же обнаружит себя. Проникшая в организм инфекция приведет к нагноению кисты и потребует срочного лечения.
Киста урахуса обычно диагностируется у мужчин, но иногда встречается и у женщин. Она требует хирургического вмешательства.
Омфалит
Это воспаление кожи, которая находится в пупочной ямке. Чаще всего эта болезнь развивается у детей, но может появиться и у взрослого человека. Заболевание возникает из-за повреждения кожи внутри пупка, в которое затем проникает инфекция. Например, это может произойти вследствие неудачно сделанного пирсинга пупка или же травмы, нанесенной в область живота.
Характерные признаки омфалита:
- запах из пупка,
- выделения из пупка,
- воспаление этой области,
- если надавить на пупочную ямку — выделяется гной,
- иногда может повыситься температура.
Что делать при появлении этих симптомов? Как можно скорее обратиться к врачу! Он назначит лечение или, при необходимости, направит в больницу.
Пупочный свищ
Это довольно редкая, чаще всего врожденная патология, которая возникает, если у ребенка не полностью затягивается пупочный канатик, происходит незаращение мочевого пузыря или же желчно-кишечного протока. Иногда встречаются и приобретенные свищи — они могут появиться из-за ранений кишки или ущемления пупочной грыжи.
Обычно это заболевание наблюдается у детей, но может возникнуть и у взрослых (как у женщин, так и у мужчин).
Характерные признаки свища:
- кожа в области пупочной ямки красная и раздражена,
- в пупке мокро и воняет, присутствуют гнойные выделения из пупка (при полном свище может также выделяться моча или кишечное содержимое),
- у человека повышена температура.
При обнаружении перечисленных выше симптомов нужно сразу же обратиться за помощью к врачу! В некоторых случаях может потребоваться проведение операции.
Кандидоз и другие грибковые инфекции
Из-за них тоже иногда воняет из пупка, а кожа вокруг него чешется и краснеет. Грибок Кандида любит теплые и влажные места, поэтому может развиваться не только на гениталиях, в кишечнике и в ротовой полости, но и в складках кожи, в том числе в пупочной ямке.
Кандидоз пупка может появиться из-за гормонального дисбаланса, в том числе во время беременности, неправильной или недостаточной гигиены, приема антибиотиков или гормональных контрацептивов, наличия диабета и других заболеваний.
Помимо неприятного запаха, в области пупочной ямки могут появиться белые творожистые выделения, покраснение кожи и зуд. Для лечения этого заболевания потребуется помощь врача.
Основные причины патологии
Рубец, который образуется на месте пуповины, на протяжении последующей жизни должен оставаться сухим. Среди причин запаха из пупка у женщины стоит отметить воспаление или наличие аномалий в мочеполовой сфере – эти проблемы у представительниц прекрасного пола диагностируются чаще всего. Сам по себе рубец в центральной части живота, как правило, не издает никакого аромата. Вне зависимости от причины, запах из пупка у женщины возникает из-за выделений.
Зловонная жидкость из рубца достаточно часто встречается во врачебной практике. Вызывать неприятный запах и выделения из пупка у женщин могут следующие факторы:
- Некачественный или нерегулярный уход за телом и пупочной зоной в частности.
- Поражение бактериальной или грибковой инфекцией.
- Нарушения мочеполовой системы.
- Воспаление на фоне хронических заболеваний.
Прежде чем приступать к лечению, врач должен разобраться в причинах, почему неприятно пахнет из пупка. Несмотря на то что этот симптом приносит немало дискомфорта, не нужно пытаться избавиться от этого симптома самостоятельно. Обязательно проконсультируйтесь с квалифицированным специалистом.
Самая банальная – инфекционное воспаление, по научному — омфалит. Живот почти постоянно находиться под тесной одеждой, прибавим сюда пот и получим темное, влажное, теплое место. Идеальная среда для развития бактерий. Чем глубже впадина, тем хуже. Поэтому от инфекционных воспалений в районе пупка часто страдают люди полные, которые много потеют и имеют очень глубокую выемку в совокупности с кожными складками.
У женщин возникают кровянистые выделения из впадины пупка. Случается это при эндометриозе, когда гормонозависимая ткань эндометрия распространяется в виде сгустков во всей внутренней полости живота. Она может поражать органы и брюшную стенку. Особенность такого состояния — периодичность выделений, связанная с менструальным циклом.
У новорожденных случается тромбофлебит вен в пупке, если после родов осуществлялись особые реанимационные мероприятия, а именно установка катетера в эту область.
Внутреннее локализованное нагноение или грыжа может привести к формированию свища. Это канал, который выделения прокладывают наружу. Они возникают также в послеоперационных рубцах.
Спровоцировать возникновение неприятно пахнущих выделений из пупочной области могут болезни мочевых путей и половых органов, а также аномалии их развития. У женщин причиной запаха из пупка с большой долей вероятности может быть:
- Киста мочевого пузыря. Проявляется данная патология возникновением болезненных ощущений в животе, стойким субфебрилитетом.
- Эндометриоз. Весьма распространенное заболевание у женщин молодого и зрелого возраста, которое характеризуется разрастанием слизистой оболочки матки и ее проникновением в брюшину. Патологию можно вылечить только хирургическим путем.
- Аномальное строение мочевыводящих протоков. Между пупком и мочевым пузырем у каждого человека есть своеобразная соединительная трубка – урахус. В норме после рождения этот проток закрывается, но иногда по причинам, в которых мы не будем разбираться, этого не происходит. В результате развивается киста или свищ урахуса, возможны проблемы с мочеиспусканием, а также появляется слизь и неприятный запах из пупка. В детстве патология может никак себя не проявить, такое действительно бывает, но рано или поздно она обнаруживается с возрастом. Вылечить аномалию можно только хирургическим путем.
— Сахарный диабет.
— Кисты щитовидной железы.
— Надпочечная недостаточность.
— Ожирение.
— Аденома щитовидной железы.
Такие заболевания приводят к нарушению работы всего организма и могут стать основной причиной, почему появляются гнойные выделения и нехорошо пахнет из пупка.
В таких случаях, помимо медикаментозного лечения, необходим пересмотр рациона питания.Исключение вредных продуктов, приводящих к нарушениям работы эндокринной системы, поможет в борьбе с болезнью.
Лечение и профилактика сахарного диабета отличается в зависимости от его степени
Надпочечная недостаточность лечится с использованием препаратов, содержащих глюкокортикоиды. При острой недостаточности оно проводится в больнице под присмотром врачей.
Причины запаха из пупа могут быть связаны с мочевым протоком.Он представляет собой трубку, проходящую от мочевого пузыря к пупку.
Важно знать! Диагностику любого заболевания проводит лечащий врач, на основании осмотра и результата анализов.
Киста мочевого пузыря не менее опасна. При ее увеличении могут появиться нагноения, неприятный аромат и повышенная температура тела.
Если из пупка выделяется жидкость с неприятным запахом у мужчин или женщин, причинами тому могут стать разные состояния. От серьезных патологических до банального несоблюдения гигиены.
Беременность
Покраснение в результате пирсинга
В момент вынашивания плода живот женщины растет. Особенно быстро в последнем триместре. От этого кожа на животе и около пупка часто не успевает подстроиться под изменения. Зона вокруг узелка воспаляется, начинает мокнуть и издавать резкий запах. Справиться с ситуацией поможет акушер-гинеколог.
Пирсинг
Молодые девушки предпочитают прокалывать не только мочки ушей, но и кожу у пупка. Процедура, проведенная в хорошем салоне, и последующий должный уход способствуют скорому заживлению раны. Если же прокол был совершен нестерильным инструментом или юная модница недостаточно хорошо обрабатывает ранку антисептиком, возможно развитие воспалительного процесса. Зона у пупка болит, припухает. Появляются гнойные выделения с резким запахом.
Пупочный свищ
Пупочный свищ
Это своеобразная открытая рана из брюшины наружу. Она является либо врожденной (незарощенный желчно-кишечный или мочевой проток), либо приобретённой. Во втором варианте к патологии приводит воспалительный процесс передней стенки брюшины. В результате формируется гнойник, который впоследствии прорывает наружу, вскрывается в зоне пупка.
Кандидоз
Грибковые заболевания развиваются на фоне эндокринных нарушений (сахарный диабет) либо по причине банального несоблюдения гигиены. При условии повышенного сахара в крови Candida активизирует свою деятельность именно там, где максимально грязно. Если человек не соблюдает правила личной гигиены, все это отягощено лишним весом, слабым иммунитетом или сахарным диабетом, не исключены выделения и резкий запах из пупка. Признаки кандидоза — белые творожистые скопления.
Плохая гигиена
Особенно это проблема встречается у подростков и людей с лишним весом. Грязь скапливается в углублении кожной складки, становится рассадником бактерий. Как результат пуп может чесаться, воспаляться, менять цвет. Особенно важно соблюдать принципы личной гигиены девушкам в момент, когда идут месячные.
Киста урахуса
Если из пупка выделяется жидкость с неприятным запахом у женщин или мужчин, причиной может быть киста урахуса — новообразование в мочевом протоке, имеющее слизистый секрет внутри. Как правило, патология является врожденной. У ребенка она незаметна, не доставляет беспокойства. Если по какой-то причине капсула подвергается инфицированию, она воспаляется и увеличивается в размерах.
Омфалит
Омфалит пупка может привести к воспалению внутренних органов
По-простому патология называется воспалением пупочных тканей. Основные ее признаки — краснота кожи вокруг искомой зоны, болезненность и припухлость, гнойные выделения, резкий запах. Иногда может течь гной с кровью в небольших количествах. Омфалит формируется при наличии запущенного грибка или инфекционных процессов. Если его не лечить, воспаление способно переброситься на внутренние органы.
Состояние, схожее с кистой урахуса. Новообразование увеличивается в размере, давит на нервные окончания пупка и постоянно раздражает их. Регулярное воздействие на ткани изнутри проводит к их воспалению. Возможно появление высокой температуры, развитие пиелонефрита, цистита и других патологий мочевыделительной системы из-за затрудненного оттока мочи. Пупок становится влажным, розоватым, может неприятно пахнуть.
Эндометриоз
Это состояние присуще только женщинам. Слизистая матки (эндометрий) на фоне гормональных изменений разрастается за пределы мышечного органа: во влагалище, трубы и даже брюшную полость. Если он достигает зоны пупка, возможно воспаление. Справиться с ситуацией можно только оперативно.
Почему может появиться запах от пупка новорожденного?
Чаще всего причинами неприятного запаха из пупка младенцев становятся осложнения при заживлении пупочной ранки и образование свищей. Оба случая требуют врачебного вмешательства.
Почему возникают трудности при заживлении пупочного кольца? В большинстве случаев виной тому неправильная гигиена: родители неправильно обрабатывают ранку, пользуются несвежими полотенцами, дотрагиваются до пупочного кольца грязными руками.
Пупочные свищи у младенцев сопровождаются теми же симптомами, что и у взрослых:
- раздражение пупочного кольца,
- покраснение кожи вокруг и внутри пупка,
- выделения гнойного характера,
- иногда возможно повышение температуры.
Инфекции и воспаление
Проникновение в организм анаэробных бактерий может приводить к воспалению пупочной области и накоплению в ней гноя. Существует несколько причин, способствующих этому:
- Из-за инфекции в пупочной области либо травмирования пупка у женщины может начаться воспалительный процесс в подкожной клетчатке (омфалит). Патология сопровождается появлением кровянистых выделений.
- У некоторых женщин аномалию может вызывать свищ. Чаще всего эта патология врожденная, но бывает и приобретенной. Во взрослом возрасте свищ образуется из-за хронического воспалительного процесса на передней стенке живота. Через какое-то время гнойные выделения, сопровождаемые зловонным запахом, выходят наружу.
- Некоторые женщины, вынашивающие малыша, замечают, что при увеличении живота из пупка начинает неприятно пахнуть, а кожа вокруг него мокреет. Аномалия возникает по причине воспалительного процесса в пупке из-за изменения его размеров.
- Проколы в области пупка (пирсинг), выполняющиеся без соблюдения правил гигиены и применения антисептиков, провоцируют появление белой жидкости с гнилостным запахом. Отсутствие своевременного лечения может привести к развитию сильного воспаления, кровотечения, сепсиса.
Если зловонные выделения приобретут гнойный характер и появятся другие симптомы (повышение температуры тела, отечность, гиперемия пупка и околопупочной области), врач вправе заподозрить омфалит. Это одна из распространенных болезней бактериального типа, спровоцированная анаэробными микроорганизмами. Выделяющийся смрадный гной при омфалите имеет желтоватый оттенок, но по мере прогрессирования болезни жидкость может стать коричневой и приобрести более густую консистенцию.
Еще одна потенциальная причина запаха из пупка у женщины кроется в поражении грибковой инфекцией. Обычно рубец сильно чешется, жжет, кожные покровы шелушатся или мокнут (в зависимости от типа возбудителя).
Среди представителей грибковой микрофлоры чаще всего встречается кандида. Этот микроб предпочитает обитать в пупке даже у здорового человека, нисколько не мешая нормальному самочувствию. Проблемы начинаются тогда, когда кандида активно размножается. Это бывает в двух случаях – на фоне ослабления иммунитета и при наличии постоянной влаги в зоне рубца. Характерной особенностью кандидоза являются творожистые выделения с кисловатым молочным ароматом.
Как избавиться от неприятного запаха из пупочной ямки?
Что делать, чтобы избавиться от запаха из пупка? Все довольно просто: необходимо соблюдать регулярную и правильную гигиену в этой области.
Как правильно мыть пупок?
Необходимо мыться каждый день, лучше с использованием жидкого средства (гель-душа, мыла), которое поможет очистить все складочки в пупочной ямке — именно их не всегда получается тщательно промыть с помощью кускового мыла.
После того, как вы помоете пупок, промокните его полотенцем, чтобы в нем не накапливалась вода. Раз в неделю обрабатывайте пупок спиртом, смочив в нем ватную палочку. Внимание! Новорожденные дети с еще не затянувшимся пупком — исключение, им обрабатывать ранку спиртом нельзя, это может привести к трудностям с заживлением.
Что делать, если запах не исчезает?
Если вы ежедневно соблюдаете гигиену, но запах все равно не исчезает, следует обязательно показаться врачу. Возможно, что проблема более серьезная, чем показалась на первый взгляд. Особенно, если вместе с неприятным запахом вы наблюдаете гнойные, кровянистые или белые выделения, боль, пупок чешется и краснеет.
Помните, игнорирование таких симптомов может привести к осложнениям, удлинению сроков лечения, внеплановой госпитализации и даже летальному исходу (в случае ущемления пупочной грыжи). Это же касается и самолечения.
Как поступить, если из пупка пахнет у младенца?
Если вы заметили, что у новорожденного пахнет из пупка или заживление ранки происходит очень медленно, ребенка необходимо показать доктору. Возможно, что произошло нагноение или развился омфалит, в этом случае малышу будут назначены дополнительные лекарства.
Что еще можно посоветовать молодым родителям?
Соблюдайте правильный уход за пупочной ранкой младенца:
- До того, как взять ребенка на руки, мойте их с мылом. Перед обработкой пупочной ранки дополнительно протирайте руки спиртом.
- Меняйте одежду младенца каждый день. После стирки не забывайте прогладить ее с 2 сторон горячим утюгом.
- Каждый день купайте малыша (для дезинфекции в воду можно добавить небольшое количество марганцовки).
- Не заклеивайте пупочную ранку пластырем — это может привести к раздражению кожи и осложнениям при заживлении.
- Поговорите с детским врачом и обрабатывайте пупок антисептиком, который он порекомендует.

Возникновение воспалительных процессов
Чаще всего пупок воспаляется при появлении свища, так как при таком явлении он мокнет. Если проявляются такие симптомы, как воспаление и покраснение в области пупа, рекомендуется сразу же обратиться к врачу.
Воспаление может возникнуть и в случае неудачного пирсинга. Следует снять сережку и обратиться к специалисту за помощью.
Также, одной из основных причин, почему у женщин может плохо пахнуть из пупка, является эндометриоз
Также, одной из основных причин, почему у женщин может плохо пахнуть из пупка, является эндометриоз. При этом воспалительном процессе проявляются такие симптомы, как тянущие боли, кровянистые выделения.
Диагностику проводит врач на осмотре, опираясь на результаты исследования выделений из пупка и анализы крови. Лечение проводят с использованием гормональных препаратов. Если после курса нет положительного результата, делают операцию.
Профилактическая обработка рубца
При заболеваниях мочеполовой сферы, спровоцировавших запах из пупка, в первую очередь занимаются их лечением. Во всех остальных случаях избавиться от такого неприятного проявления можно, ежедневно промывая рубец мягкой мочалкой с мылом, а после водных процедур – дезинфицируя «Хлоргексидином» или «Мирамистином». Женщине, особенно с избыточным весом, важно не допускать образования в пупке грязевых пробок.
В современном мире следить за чистотой тела не так сложно: у каждого в доме есть ванная или душ, а в частном доме строят и бани. При желании человек может мыться не только каждый день, но и несколько раз в день. Почему же тогда появляется неприятный запах из пупка? И как от него избавиться?
Какие симптомы возникают вместе с запахом
В тех случаях, когда соблюдение перечисленных правил гигиены не решает проблему зловонного запаха, нужно предположить, что он вызван другой причиной. Правильно её определить помогут другие проявления болезни.
Вместе с плохим запахом у женщины могут наблюдаться такие явления:
Если кроме запаха проявилось хотя бы несколько из вышеуказанных симптомов, стоит отказаться от самостоятельного лечения и отправиться к врачу.